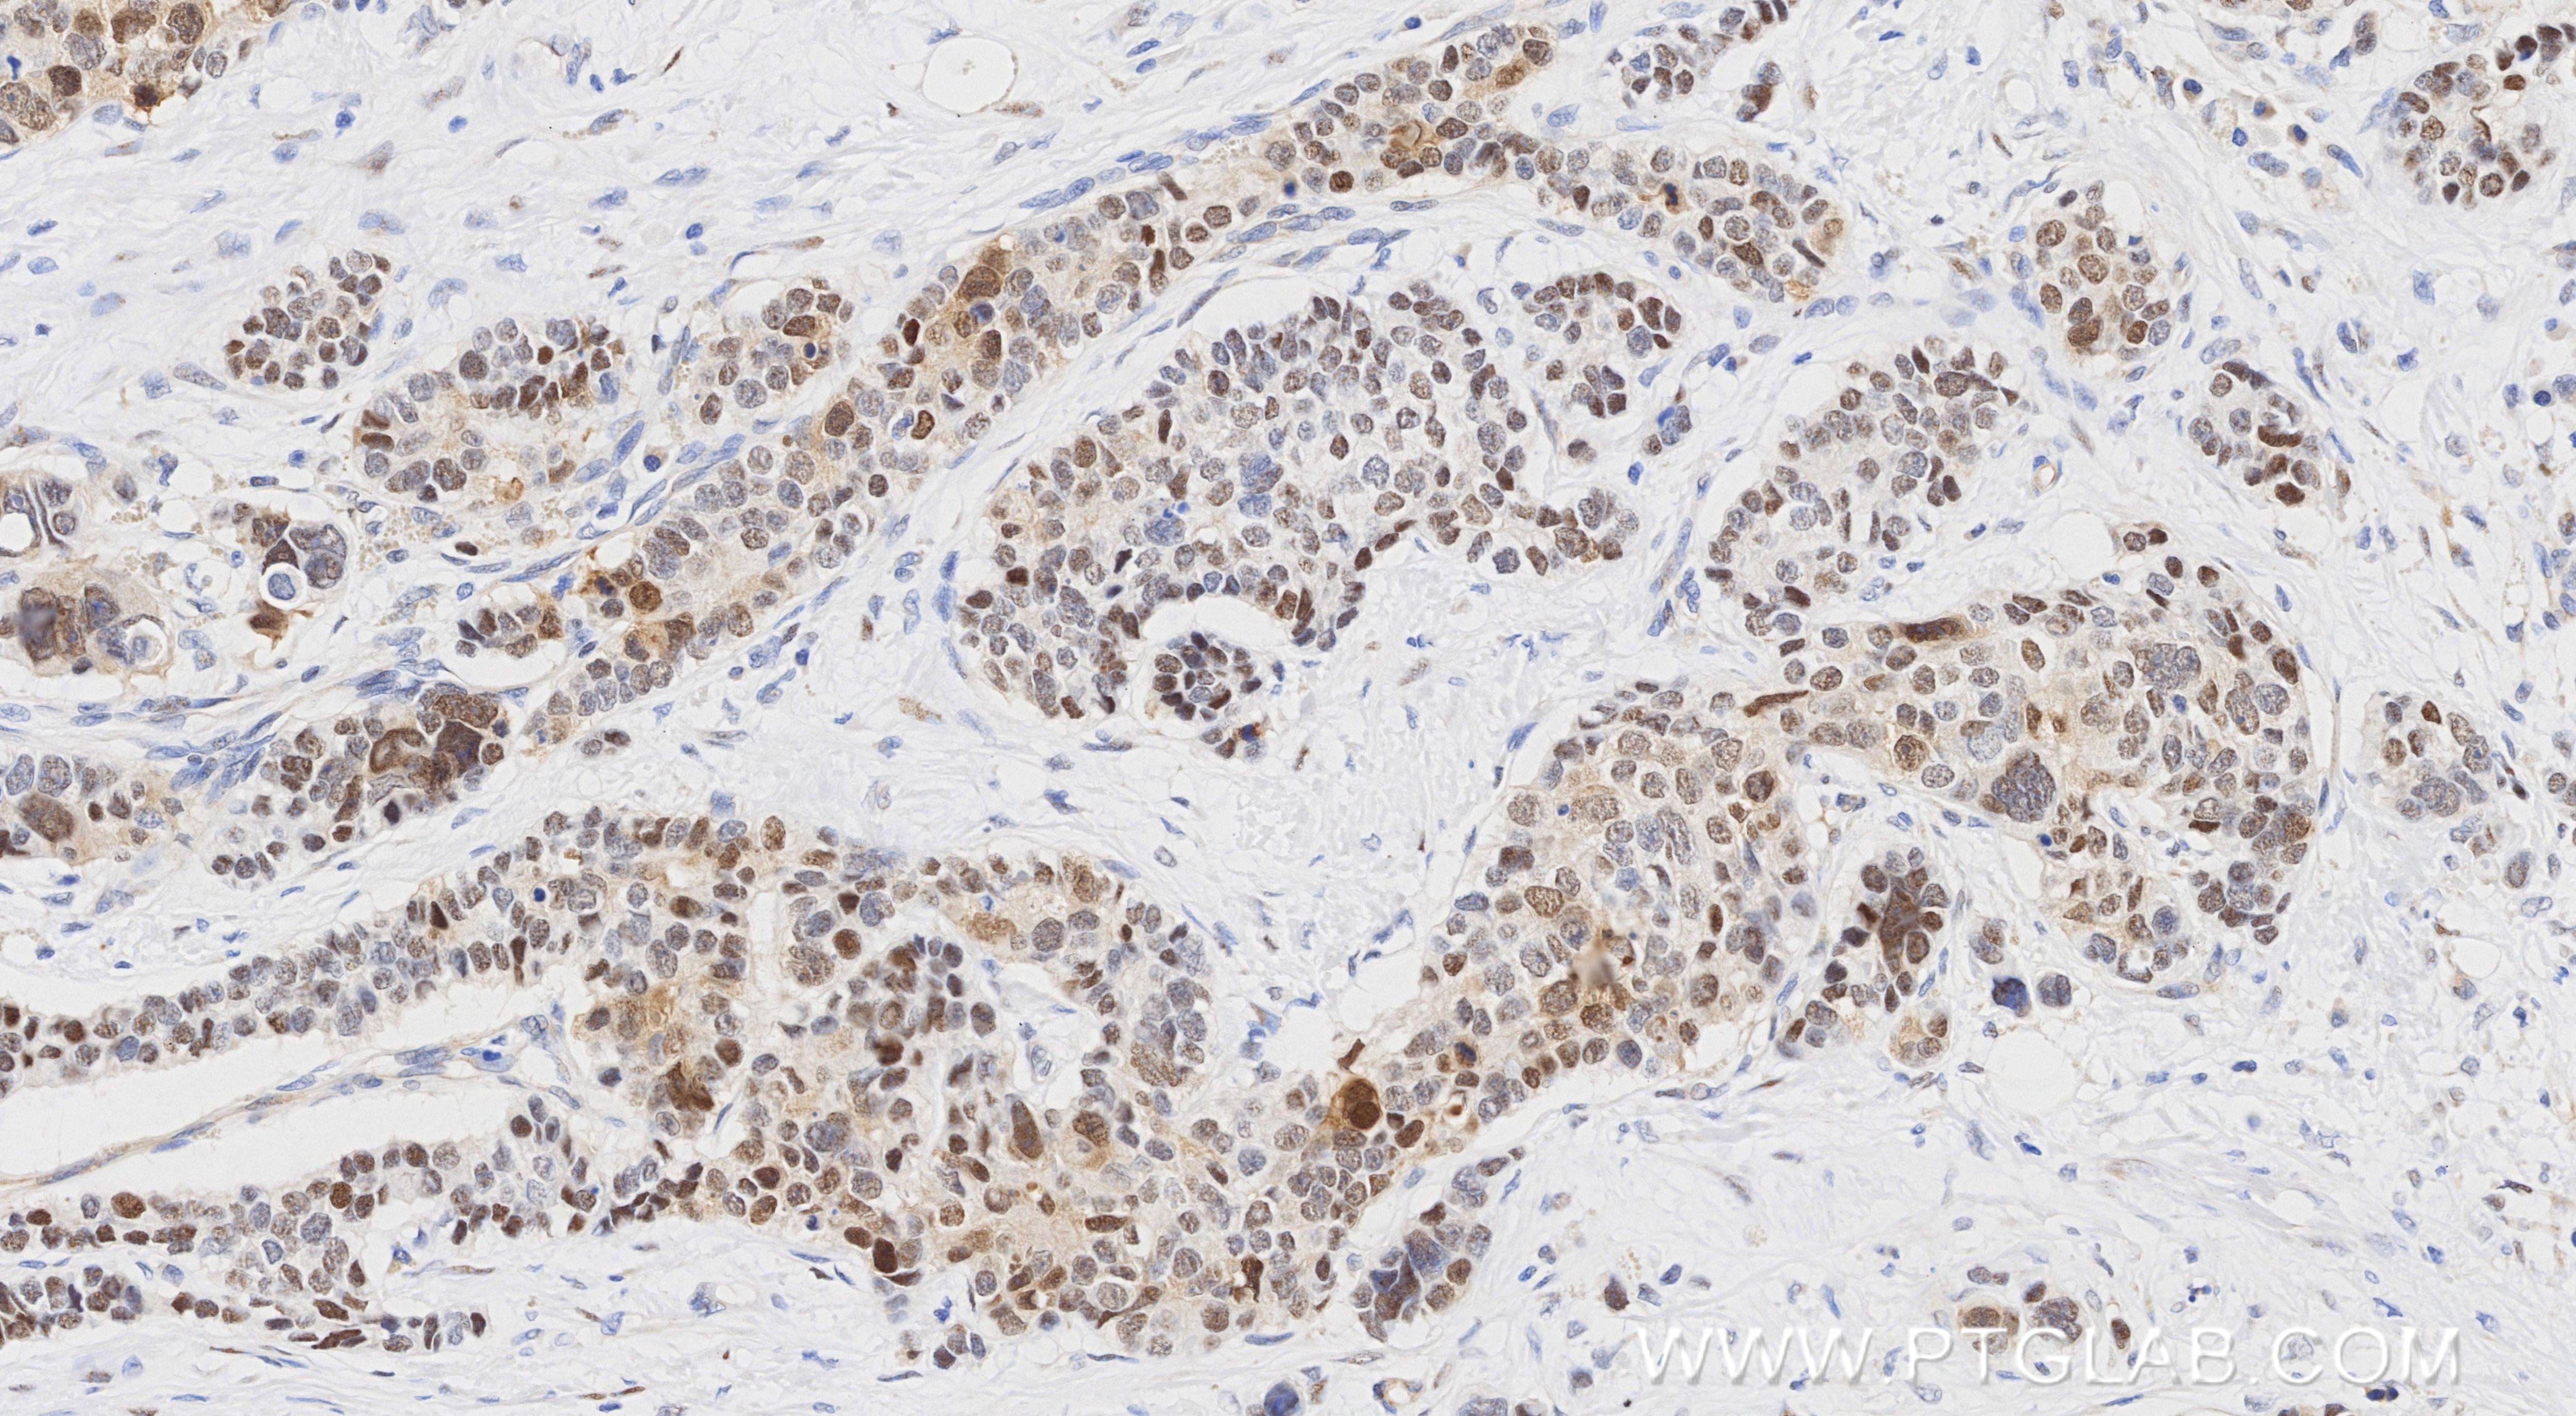
Immunohistochemistry (IHC) staining of human stomach cancer tissue using UBE2T/HSPC150 Recombinant monoclonal antibody (86278-1-RR)

Product Information
86278-1-PBS targets UBE2T/HSPC150 in WB, IHC, Indirect ELISA applications and shows reactivity with human samples.
| Tested Reactivity | human |
| Host / Isotype | Rabbit / IgG |
| Class | Recombinant |
| Type | Antibody |
| Immunogen |
CatNo: Ag0153 Product name: Recombinant human UBE2T protein Source: e coli.-derived, PGEX-4T Tag: GST Domain: 2-190 aa of BC004152 Sequence: QRASRLKRELHMLATEPPPGITCWQDKDQMDDLRAQILGGANTPYEKGVFKLEVIIPERYPFEPPQIRFLTPIYHPNIDSAGRICLDVLKLPPKGAWRPSLNIATVLTSIQLLMSEPNPDDPLMADISSEFKYNKPAFLKNARQWTEKHARQKQKADEEEMLDNLPEAGDSRVHNSTQKRKASQLVGIE Predict reactive species |
| Full Name | ubiquitin-conjugating enzyme E2T (putative) |
| Calculated Molecular Weight | 23 kDa |
| Observed Molecular Weight | 23 kDa |
| GenBank Accession Number | BC004152 |
| Gene Symbol | UBE2T |
| Gene ID (NCBI) | 29089 |
| Conjugate | Unconjugated |
| Form | Liquid |
| Purification Method | Protein A purification |
| UNIPROT ID | Q9NPD8 |
| Storage Buffer | PBS only, pH 7.3. |
| Storage Conditions | Store at -80°C. |
Background Information
uitin (Ub)-mediated protein degradation pathway involves three sequential enzymatic steps that facilitate the conjugation of Ub to specific protein substrates. The first step requires ATP-dependent activation of the C-terminus of Ub and the assembly of multi-Ubs by Ub-activating enzyme E1. The ubiquitin-conjugating enzyme E2, catalytic (UBCc) domain, is then conjugated to Ubs, through a thiol-ester linkage between a conserved cysteine and the C-terminus of Ub, to generate an intermediate Ub-E2 complex. Then the E3, a ligase, catalyzes the transfer of Ub from E2 to the appropriate substrate. This pathway regulates many fundamental cellular processes. There are also other E2s which form thiol-ester linkages without the use of E3s as well as several UBC homologs (TSG101, Mms2, Croc-1 and similar proteins), which lack the active site cysteine essential for ubiquitination and appear to function in DNA repair pathways.